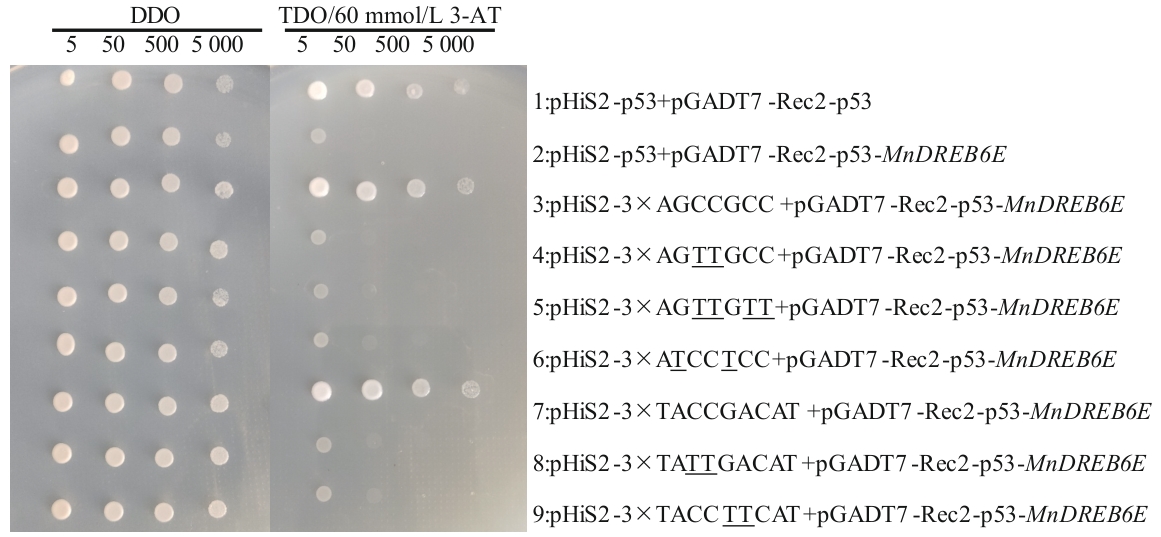

生物技术通报 ›› 2026, Vol. 42 ›› Issue (2): 306-316.doi: 10.13560/j.cnki.biotech.bull.1985.2025-0705
收稿日期:2025-07-01
出版日期:2026-02-26
发布日期:2026-03-17
通讯作者:
刘惠芬,女,博士,副研究员,研究方向 :昆虫病理;E-mail: liuhuifen77@163.com作者简介:董亚茹,女,硕士,助理研究员,研究方向 :桑树栽培与育种;E-mail: dongyaru2013@126.com
基金资助:
DONG Ya-ru( ), ZHU Hong, WANG Zhao-hong, ZHAO Dong-xiao, LIU Hui-fen(
), ZHU Hong, WANG Zhao-hong, ZHAO Dong-xiao, LIU Hui-fen( )
)
Received:2025-07-01
Published:2026-02-26
Online:2026-03-17
摘要:
目的 解析桑树DREB转录因子家族成员MnDREB6E的生物学功能,阐明其在非生物胁迫响应中的作用机制,为木本植物抗逆分子育种提供基因资源。 方法 基于桑树盐胁迫转录组数据克隆MnDREB6E,通过生物信息学分析其序列特征及系统进化关系;利用酵母单杂交技术分析其顺式作用元件;构建过表达及抑制表达载体,采用农杆菌瞬时转化技术获得转基因植株,测定盐/干旱胁迫下生理生化指标及相关基因表达水平。 结果 MnDREB6E开放阅读框(ORF)全长1 173 bp,编码390个氨基酸,具有典型AP2/ERF结构域,归属DREB A6亚组;MnDREB6E亚细胞定位预测在细胞核,可特异性结合GCC-box/DRE顺式元件;盐/干旱胁迫下,过表达植株的超氧化物歧化酶(SOD)、过氧化氢酶(CAT)、过氧化物酶(POD)、谷胱甘肽S-转移酶(GST)活性显著提高,抗坏血酸(AsA)、还原型谷胱甘肽(GSH)和脯氨酸含量增加,超氧阴离子(O2•-)、过氧化氢(H2O2)、羟自由基(•OH)水平降低,相对电导率和丙二醛含量下降,相关抗氧化酶基因表达显著上调。 结论 MnDREB6E通过协同调控抗氧化代谢与渗透保护通路,正向增强桑树对盐/干旱胁迫耐受性。
董亚茹, 朱红, 王照红, 赵东晓, 刘惠芬. 桑树MnDREB6E的克隆及耐盐抗旱性分析[J]. 生物技术通报, 2026, 42(2): 306-316.
DONG Ya-ru, ZHU Hong, WANG Zhao-hong, ZHAO Dong-xiao, LIU Hui-fen. Cloning and Salt-drought Tolerance Analysis of MnDREB6E Gene in Mulberry[J]. Biotechnology Bulletin, 2026, 42(2): 306-316.
| 引物名称 Primer name | 序列 Sequence (5′‒3′) | 用途 Application |
|---|---|---|
| MnDREB6E-F | ATGGAAGATCAGTTTCCCAAGATG | 基因克隆 Gene cloning |
| MnDREB6E-R | TCATGATGTATCAGAGACCAG | |
| pROKⅡ-MnDREB6E-F | CTCTAGAGGATCCCCATGGAAGATCAGTTTCCCAAG | 载体构建 Vector construction |
| pROKⅡ-MnDREB6E-R | TCGAGCTCGGTACCCTCATGATGTATCAGAGACCAG | |
| pFGC5941-MnDREB6E-cis-F | ACAATTACCATGGGGCGTCATCGGTTTCATCACCGGG | |
| pFGC5941-MnDREB6E-cis-R | AAATCATCGATTGGGCCACTCTTTTCTTGTGGGGTTG | |
| pFGC5941-MnDREB6E-anti-F | AGTTAATTAAGACCCCGTCATCGGTTTCATCACCGGG | |
| pFGC5941-MnDREB6E-anti-R | CTAGGGACTAGTCCCCCACTCTTTTCTTGTGGGGTTG | |
| pGADT7-Rec2-F | ATGAACATGGAGGCCAGTG | |
| pGADT7-Rec2-R | GATGGATCCCGTATCGATG | |
| pHIS2-F | GCCTTCGTTTATCTTGCCTGCTC | |
| pHIS2-R | CGATCGGTGCGGGCCTCTTC |
表1 基因克隆和载体构建所用引物
Table 1 Primers used in gene cloning and vector construction
| 引物名称 Primer name | 序列 Sequence (5′‒3′) | 用途 Application |
|---|---|---|
| MnDREB6E-F | ATGGAAGATCAGTTTCCCAAGATG | 基因克隆 Gene cloning |
| MnDREB6E-R | TCATGATGTATCAGAGACCAG | |
| pROKⅡ-MnDREB6E-F | CTCTAGAGGATCCCCATGGAAGATCAGTTTCCCAAG | 载体构建 Vector construction |
| pROKⅡ-MnDREB6E-R | TCGAGCTCGGTACCCTCATGATGTATCAGAGACCAG | |
| pFGC5941-MnDREB6E-cis-F | ACAATTACCATGGGGCGTCATCGGTTTCATCACCGGG | |
| pFGC5941-MnDREB6E-cis-R | AAATCATCGATTGGGCCACTCTTTTCTTGTGGGGTTG | |
| pFGC5941-MnDREB6E-anti-F | AGTTAATTAAGACCCCGTCATCGGTTTCATCACCGGG | |
| pFGC5941-MnDREB6E-anti-R | CTAGGGACTAGTCCCCCACTCTTTTCTTGTGGGGTTG | |
| pGADT7-Rec2-F | ATGAACATGGAGGCCAGTG | |
| pGADT7-Rec2-R | GATGGATCCCGTATCGATG | |
| pHIS2-F | GCCTTCGTTTATCTTGCCTGCTC | |
| pHIS2-R | CGATCGGTGCGGGCCTCTTC |
基因 Gene | 正向引物 Forward primer (5′‒3′) | 反向引物 Reverse primer (5′‒3′) |
|---|---|---|
| MnDREB6E | CCAAATCAAAAGAACAAGCCT | ATTCTACTCAGCTGAACAGCT |
| MnRPL15 | GGCTATGTGATTTACCGTGTT | TTGGTCCAGTATGAGTTGAGAA |
| β-actin | AGCAACTGGGATGACATGGAGA | CGACCACTGGCGTAAAGGGA |
| sodc | GCAGCACCAAAGCCACTCT | CCGTCGTCTTGTTGGGTCA |
| sod1 | GACGCTGATGAGAAAGGT | TTAGACCTTGCCGGTGAC |
| mpod12 | CCCCACGAACATCACGGTTGCCACTA | GCACGTATCTCACCTTGGCTGCCTGT |
| pod4 | TCCCCTCTCGACAGCACC | AGTTTACCACCACGCAAT |
| cat1 | CGTCACGCTGAGAGGTAC | TCAAATGCTTGGCCTCAC |
| gst10 | GCCCTAGGTGACAAAGAT | CTACTCAATGCCATTCAT |
表2 实时荧光定量PCR引物序列
Table 2 Primer sequences for RT-qPCR
基因 Gene | 正向引物 Forward primer (5′‒3′) | 反向引物 Reverse primer (5′‒3′) |
|---|---|---|
| MnDREB6E | CCAAATCAAAAGAACAAGCCT | ATTCTACTCAGCTGAACAGCT |
| MnRPL15 | GGCTATGTGATTTACCGTGTT | TTGGTCCAGTATGAGTTGAGAA |
| β-actin | AGCAACTGGGATGACATGGAGA | CGACCACTGGCGTAAAGGGA |
| sodc | GCAGCACCAAAGCCACTCT | CCGTCGTCTTGTTGGGTCA |
| sod1 | GACGCTGATGAGAAAGGT | TTAGACCTTGCCGGTGAC |
| mpod12 | CCCCACGAACATCACGGTTGCCACTA | GCACGTATCTCACCTTGGCTGCCTGT |
| pod4 | TCCCCTCTCGACAGCACC | AGTTTACCACCACGCAAT |
| cat1 | CGTCACGCTGAGAGGTAC | TCAAATGCTTGGCCTCAC |
| gst10 | GCCCTAGGTGACAAAGAT | CTACTCAATGCCATTCAT |

图1 MnDREB6E的克隆M:DNA marker DL 2 000;1:阴性对照;2:MnDREB6E条带
Fig. 1 Cloning of MnDREB6E geneM: DNA marker DL 2 000; 1: negative control; 2: MnDREB6E gene band

图2 MnDREB6E与拟南芥A6组蛋白序列比对绿色线条代表保守的DNA结合结构域(AP2/ERF结构域),3个红色方框、1个蓝色方框和▲符号分别表示3个β折叠片层、1个α螺旋结构以及V14位点
Fig. 2 Sequence alignment of MnDREB6E with protein sequences from group A6 of Arabidopsis thalianaThe green line indicates the conserved DNA-binding domain (AP2/ERF domain), 3 red boxes, 1 blue box and ▲ respectively indicate 3 β-sheets, 1 α-helix and V14

图3 MnDREB6与拟南芥、水稻、玉米、胡杨、棉花、大豆DREB家族蛋白的系统进化关系
Fig. 3 Phylogenetic relationships between MnDREB6 and DREB family proteins from A. thaliana, Oryza sativa, Zea mays, Populus euphratica, Gossypium hirsutum, and Glycine max
图4 MnDREB6E结合GCC-box和DRE顺式元件分析阳性对照、阴性对照和试验菌体分别稀释5、50、500和5 000倍,TDO(SD/-His/-Leu/-Trp)固体培养基含有60 mmol/L 3-AT;1是阳性对照,2是阴性对照,3和7分别是GCC-box和DRE核心序列,4-6和8-9分别是GCC-box和DRE的核心突变序列
Fig. 4 Analyses of MnDREB6E binding to GCC-box and DRE motifsThe positive control, negative control, and experimental bacterial cells were diluted 5, 50, 500, and 5 000 fold respectively. The TDO (SD/-His/-Leu/-Trp) solid medium contained 60 mmol/L 3-AT; 1 refers to the positive control, 2 refers to the negative control, 3 and 7 correspond to the GCC-box and DRE core sequences respectively, while 4‒6 and 8‒9 refer to core mutant sequences of GCC-box and DRE motifs

图5 MnDREB6E瞬时转化桑树植株的RT-qPCR检测A和B分别为盐和干旱胁迫处理下瞬时转化桑树植株MnDREB6E表达量。*表示在P<0.05水平上差异显著。下同
Fig. 5 RT-qPCR detection of mulberry transiently transformed with MnDREB6EA and B are the expressions of the MnDREB6E gene in transiently transformed mulberry plants under salt and drought stress treatments, respectively. * indicates significantly different at the P<0.05 level. The same below

图6 逆境胁迫下Control、OE及RNAi桑树植株中相对电导率及MDA含量分析A:盐胁迫处理;B:干旱胁迫处理
Fig. 6 Analysis of electrolyte permeability and MDA content in Control, OE and RNAi mulberry plants under stress conditionsA: Salt stress treatment. B: Drought stress treatment

图7 逆境胁迫下Control、OE及RNAi桑树植株中O2•-、H2O2和•OH含量的变化A:盐胁迫处理;B:干旱胁迫处理
Fig. 7 Changes in the contents of O2•-, H2O2, and •OH in Control, OE and RNAi mulberry plants under stress conditionsA: Salt stress treatment. B: Drought stress treatment

图8 逆境胁迫下Control、OE及RNAi桑树植株中SOD、POD、CAT和GST活性的变化A:盐胁迫处理;B:干旱胁迫处理
Fig. 8 Changes in the activities of SOD, POD, CAT and GST in Control, OE and RNAi mulberry plants under stress conditionsA: Salt stress treatment. B: Drought stress treatment

图9 逆境胁迫下Control、OE及RNAi桑树植株中AsA、GSH和脯氨酸含量的变化A:盐胁迫处理;B:干旱胁迫处理
Fig. 9 Changes in the contents of AsA, GSH and proline in Control, OE and RNAi mulberry plants under stress conditionsA: Salt stress treatment. B: Drought stress treatment

图10 逆境胁迫下Control、OE及RNAi桑树植株中氧化酶基因表达分析A:盐胁迫处理(48 h);B:干旱胁迫处理(48 h)
Fig. 10 Analysis of oxidase gene expression in Control, OE and RNAi mulberry plants under stress conditionsA: Salt stress treatment (48 h). B: Drought stress treatment (48 h)
| [1] | 黄先智, 秦俭, 沈以红. 中国桑树生态产业研究 [M]. 北京: 中国农业出版社, 2017. |
| Huang XZ, Qin J, Shen YH. Study on mulberry ecological industry in China [M]. Beijing: China Agriculture Press, 2017. | |
| [2] | 宋子荷, 甄艳. 植物干旱和盐胁迫响应相关miRNA研究进展 [J]. 南京林业大学学报: 自然科学版, 2024, 48(4): 1-11. |
| Song ZH, Zhen Y. Advancements in the research of miRNAs associated with plant drought and salt stress responses [J]. J Nanjing For Univ Nat Sci Ed, 2024, 48(4): 1-11. | |
| [3] | 陈彩锦, 马琳, 包明芳, 等. WRKY基因家族在植物中的研究进展 [J]. 草地学报, 2025, 33(7): 2059-2069. |
| Chen CJ, Ma L, Bao MF, et al. Research progress on the role of WRKY family genes in plants [J]. Acta Agrestia Sin, 2025, 33(7): 2059-2069. | |
| [4] | Sadau SB, Liu ZX, Ninkuu V, et al. DREB transcription factors are crucial regulators of abiotic stress responses in Gossypium spp [J]. Plant Stress, 2024, 11: 100350. |
| [5] | Haddoudi L, Ayadi M, Hdira S, et al. Genome-wide characterization of DREB transcription factors in Medicago truncatula: Insights into their roles in development and abiotic stress response [J]. Gene Rep, 2025, 39: 102170. |
| [6] | Liang JX, Zhou LY, Hu X, et al. Functional and expression profiling of DREB genes in Ma Bamboo (Dendrocalamus latiflorus Munro) reveals their role in abiotic stress adaptation [J]. Plant Physiol Biochem, 2025, 228: 110203. |
| [7] | Sakuma Y, Liu Q, Dubouzet JG, et al. DNA-binding specificity of the ERF/AP2 domain of Arabidopsis DREBs, transcription factors involved in dehydration- and cold-inducible gene expression [J]. Biochem Biophys Res Commun, 2002, 290(3): 998-1009. |
| [8] | Erpen L, Devi HS, Grosser JW, et al. Potential use of the DREB/ERF, MYB, NAC and WRKY transcription factors to improve abiotic and biotic stress in transgenic plants [J]. Plant Cell Tissue Organ Cult, 2018, 132(1): 1-25. |
| [9] | Gilmour SJ, Zarka DG, Stockinger EJ, et al. Low temperature regulation of the Arabidopsis CBF family of AP2 transcriptional activators as an early step in cold-induced COR gene expression [J]. Plant J, 1998, 16(4): 433-442. |
| [10] | Liu Q, Kasuga M, Sakuma Y, et al. Two transcription factors, DREB1 and DREB2 with an EREBP/AP2 DNA binding domain separate two cellular signal transduction pathways in drought- and low-temperature-responsive gene expression, respectively, in Arabidopsis [J]. Plant Cell, 1998, 10(8): 1391-1406. |
| [11] | Medina J, Bargues M, Terol J, et al. The Arabidopsis CBF gene family is composed of three genes encoding AP2 domain-containing proteins whose expression is regulated by low temperature but not by abscisic acid or dehydration [J]. Plant Physiol, 1999, 119(2): 463-470. |
| [12] | Dubouzet JG, Sakuma Y, Ito Y, et al. OsDREB genes in rice, Oryza sativa L., encode transcription activators that function in drought-, high-salt- and cold-responsive gene expression [J]. Plant J, 2003, 33(4): 751-763. |
| [13] | Matsukura S, Mizoi J, Yoshida T, et al. Comprehensive analysis of rice DREB2-type genes that encode transcription factors involved in the expression of abiotic stress-responsive genes [J]. Mol Genet Genomics, 2010, 283(2): 185-196. |
| [14] | Kume S, Kobayashi F, Ishibashi M, et al. Differential and coordinated expression of Cbf and Cor/Lea genes during long-term cold acclimation in two wheat cultivars showing distinct levels of freezing tolerance [J]. Genes Genet Syst, 2005, 80(3): 185-197. |
| [15] | Liu SX, Wang XL, Wang HW, et al. Genome-wide analysis of ZmDREB genes and their association with natural variation in drought tolerance at seedling stage of Zea mays L [J]. PLoS Genet, 2013, 9(9): e1003790. |
| [16] | Mizoi J, Ohori T, Moriwaki T, et al. GmDREB2A;2, a canonical DEHYDRATION-RESPONSIVE ELEMENT-BINDING PROTEIN2-type transcription factor in soybean, is posttranslationally regulated and mediates dehydration-responsive element-dependent gene expression [J]. Plant Physiol, 2013, 161(1): 346-361. |
| [17] | Chen M, Wang QY, Cheng XG, et al. GmDREB2, a soybean DRE-binding transcription factor, conferred drought and high-salt tolerance in transgenic plants [J]. Biochem Biophys Res Commun, 2007, 353(2): 299-305. |
| [18] | Liu K, Yang Q, Yang TR, et al. Transcriptome-based identification and expression profiling of AP2/ERF members in Caragana intermedia and functional analysis of CiDREB3 [J]. Mol Biol Rep, 2021, 48(12): 7953-7965. |
| [19] | Geng LZ, Ren J, Ji XL, et al. Over-expression of DREB46 enhances drought tolerance in Populus trichocarpa [J]. J Plant Physiol, 2023, 281: 153923. |
| [20] | Liao X, Guo X, Wang Q, et al. Overexpression of MsDREB6.2 results in cytokinin-deficient developmental phenotypes and enhances drought tolerance in transgenic apple plants [J]. Plant J, 2017, 89(3): 510-526. |
| [21] | Du XP, Li WY, Sheng LP, et al. Over-expression of Chrysanthemum CmDREB6 enhanced tolerance of Chrysanthemum to heat stress [J]. BMC Plant Biol, 2018, 18(1): 178. |
| [22] | Zhu M, Zheng LM, Cao SL, et al. AnDREB5.1, a A5 group DREB gene from desert shrub Ammopiptanthus nanus, confers osmotic and cold stress tolerances in transgenic tobacco [J]. Physiol Plant, 2024, 176(2): e14272. |
| [23] | Yang MM, Liu L, Li MH, et al. Dehydration-responsive element-binding transcription factor, GuDREB35, positively regulates drought tolerance in licorice (Glycyrrhiza uralensis) [J]. Int J Biol Macromol, 2025, 306: 141829. |
| [24] | 韩芳英, 胡昕, 王楠楠, 等. DREBs响应植物非生物逆境胁迫研究进展 [J]. 生物技术通报, 2023, 39(11): 86-98. |
| Han FY, Hu X, Wang NN, et al. Research progress in response of DREBs to abiotic stress in plant [J]. Biotechnol Bull, 2023, 39(11): 86-98. | |
| [25] | 韩刚, 贾园园, 朱祯煜, 等. 刚毛柽柳ThZFP3基因的耐盐抗旱功能 [J]. 中南林业科技大学学报, 2024, 44(8): 139-149. |
| Han G, Jia YY, Zhu ZY, et al. Salt tolerance and drought resistance function of ThZFP3 gene in Tamarix hispida [J]. J Cent South Univ For Technol, 2024, 44(8): 139-149. | |
| [26] | 董亚茹, 赵东晓, 耿兵, 等. 桑树MnERF2的表达分析 [J]. 生物技术通报, 2022, 38(11): 112-121. |
| Dong YR, Zhao DX, Geng B, et al. Expression analysis of MnERF2 in mulberry [J]. Biotechnol Bull, 2022, 38(11): 112-121. | |
| [27] | Zhang X, Yu JJ, Qu GZ, et al. The cold-responsive C-repeat binding factors in Betula platyphylla Suk. positively regulate cold tolerance [J]. Plant Sci, 2024, 341: 112012. |
| [28] | Wang PL, Wang DN, Li YX, et al. The transcription factor ThDOF8 binds to a novel cis-element and mediates molecular responses to salt stress in Tamarix hispida [J]. J Exp Bot, 2024, 75(10): 3171-3187. |
| [29] | Wang YQ, Xia DN, Li WQ, et al. Overexpression of a tomato AP2/ERF transcription factor SlERF.B1 increases sensitivity to salt and drought stresses [J]. Sci Hortic, 2022, 304: 111332. |
| [30] | Jouve L, Engelmann F, Noirot M, et al. Evaluation of biochemical markers (sugar, proline, malonedialdehyde and ethylene) for cold sensitivity in microcuttings of two coffee species [J]. Plant Sci, 1993, 91(1): 109-116. |
| [31] | Li BB, Wang XH, Wang XF, et al. An AP2/ERF transcription factor VvERF63 positively regulates cold tolerance in Arabidopsis and grape leaves [J]. Environ Exp Bot, 2023, 205: 105124. |
| [32] | Apel K, Hirt H. Reactive oxygen species: metabolism, oxidative stress, and signal transduction [J]. Annu Rev Plant Biol, 2004, 55: 373-399. |
| [33] | Lv KW, Li J, Zhao K, et al. Overexpression of an AP2/ERF family gene, BpERF13, in birch enhances cold tolerance through upregulating CBF genes and mitigating reactive oxygen species [J]. Plant Sci, 2020, 292: 110375. |
| [34] | Miller G, Suzuki N, CIFTCI-YILMAZ S, et al. Reactive oxygen species homeostasis and signalling during drought and salinity stresses [J]. Plant Cell Environ, 2010, 33(4): 453-467. |
| [35] | Xu SC, Ding HD, Sang JR. Reactive oxygen species, metabolism, and signal transduction in plant cells [J]. Acta Bot Yunnanica, 2007, 29(3): 355-365. |
| [36] | de la Cruz Jiménez J, Cardoso JA, Dominguez M, et al. Morpho-anatomical traits of root and non-enzymatic antioxidant system of leaf tissue contribute to waterlogging tolerance in Brachiaria grasses [J]. Grassland Sci, 2015, 61(4): 243-252. |
| [37] | Li C, Cui J, Shen YR, et al. BrERF109 positively regulates the tolerances of drought and salt stress in Chinese cabbage [J]. Environ Exp Bot, 2024, 223: 105794. |
| [38] | Oakley A. Glutathione transferases: a structural perspective [J]. Drug Metab Rev, 2011, 43(2): 138-151. |
| [39] | Islam S, Sajib SD, Jui ZS, et al. Genome-wide identification of glutathione S-transferase gene family in pepper, its classification, and expression profiling under different anatomical and environmental conditions [J]. Sci Rep, 2019, 9(1): 9101. |
| [40] | 高子奇, 汤宇晨, 郑琳琳, 等. 异源过表达NtCIPK5提高转基因拟南芥对盐和干旱胁迫的耐受性 [J]. 植物生理学报, 2023, 59(12): 2320-2332. |
| Gao ZQ, Tang YC, Zheng LL, et al. Heterologous overexpression of NtCIPK5 improves the tolerance to salt and drought stresses in Arabidopsis thaliana [J]. Plant Physiol J, 2023, 59(12): 2320-2332. | |
| [41] | Yang GY, Peng SB, Wang TY, et al. Walnut ethylene response factor JrERF2-2 interact with JrWRKY7 to regulate the GSTs in plant drought tolerance [J]. Ecotoxicol Environ Saf, 2021, 228: 112945. |
| [42] | 罗巧玉, 谢惠春, 马永贵, 等. 水分胁迫对发草抗坏血酸‒谷胱甘肽循环的影响 [J]. 草业科学, 2025, 42(6): 1477-1485. |
| Luo QY, Xie HC, Ma YG, et al. Effects of drought and waterlogging stress on the ascorbate-glutathione cycle of hairgrass [J]. Pratacultural Sci, 2025, 42(6): 1477-1485. | |
| [43] | El Moukhtari A, Cabassa-Hourton C, Farissi M, et al. How does proline treatment promote salt stress tolerance during crop plant development [J]. Front Plant Sci, 2020, 11: 1127. |
| [1] | 殷亚龙, 张明洋, 王洁敏, 苗雪雪, 陈劲, 王伟平. 水稻非生物胁迫协同耐受机制研究进展[J]. 生物技术通报, 2026, 42(4): 26-37. |
| [2] | 刘青媛, 吴洪启, 陈秀娥, 陈剑, 姜远泽, 何燕子, 喻奇伟, 刘仁祥. 转录因子NtMYB96a调控烟草耐旱性的功能研究[J]. 生物技术通报, 2026, 42(4): 239-250. |
| [3] | 张冬岭, 张寅生, 王建军, 叶飞宇, 卢子涵, 马晨晨, 柳华峰, 胡德升, 邓亚洲, 曹丽茹. 玉米HSFs转录因子家族在干旱胁迫下的表达特性及功能[J]. 生物技术通报, 2026, 42(2): 178-187. |
| [4] | 农韦优, 赵昌祖, 钱禛锋, 丁倩, 王誉洁, 陈疏影, 何丽莲, 李富生. 蔗茅EfBBX基因家族鉴定及冷胁迫下表达模式分析[J]. 生物技术通报, 2026, 42(2): 267-277. |
| [5] | 任云儿, 伍国强, 成斌, 魏明. 甜菜BvATGs基因家族全基因组鉴定及盐胁迫下表达模式分析[J]. 生物技术通报, 2026, 42(1): 184-197. |
| [6] | 张月, 戴月华, 张莹莹, 李奥辉, 李楚慧, 薛金爱, 秦慧彬, 陈妍, 聂萌恩, 张海平. 大豆烯酰辅酶A还原酶ECR14基因的克隆与功能分析[J]. 生物技术通报, 2026, 42(1): 95-104. |
| [7] | 巩慧玲, 邢玉洁, 马俊贤, 蔡霞, 冯再平. 马铃薯LAC基因家族的鉴定及盐胁迫下表达分析[J]. 生物技术通报, 2025, 41(9): 82-93. |
| [8] | 李雅琼, 格桑拉毛, 陈启迪, 杨宇环, 何花转, 赵耀飞. 异源过表达高粱SbSnRK2.1增强拟南芥对盐胁迫的抗性[J]. 生物技术通报, 2025, 41(8): 115-123. |
| [9] | 李开杰, 吴瑶, 李丹丹. 红花CtbHLH128基因克隆及调控干旱胁迫应答功能研究[J]. 生物技术通报, 2025, 41(8): 234-241. |
| [10] | 程雪, 付颖, 柴晓娇, 王红艳, 邓欣. 谷子LHC基因家族鉴定及非生物胁迫表达分析[J]. 生物技术通报, 2025, 41(8): 102-114. |
| [11] | 付博晗, 毛华, 赵薪程, 陆虹, 欧庸彬, 姚银安. 不同杨树SOS1基因启动子的克隆及盐胁迫响应分析[J]. 生物技术通报, 2025, 41(7): 205-213. |
| [12] | 王芳, 乔帅, 宋伟, 崔鹏娟, 廖安忠, 谭文芳, 杨松涛. 甘薯IbNRT2基因家族全基因组鉴定和表达分析[J]. 生物技术通报, 2025, 41(7): 193-204. |
| [13] | 魏雨佳, 李岩, 康语涵, 弓晓楠, 杜敏, 涂岚, 石鹏, 于子涵, 孙彦, 张昆. 白颖苔草CrMYB4基因的克隆和表达分析[J]. 生物技术通报, 2025, 41(7): 248-260. |
| [14] | 张泽, 杨秀丽, 宁东贤. 花生4CL基因家族鉴定及对干旱与盐胁迫响应分析[J]. 生物技术通报, 2025, 41(7): 117-127. |
| [15] | 李新妮, 李俊怡, 马雪华, 何卫, 李佳丽, 于佳, 曹晓宁, 乔治军, 刘思辰. 谷子果胶甲酯酶抑制子PMEI基因家族鉴定及其对非生物胁迫的响应分析[J]. 生物技术通报, 2025, 41(7): 150-163. |
| 阅读次数 | ||||||
|
全文 |
|
|||||
|
摘要 |
|
|||||